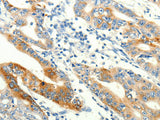
TRPA1 Polyclonal Antibody Store at -20°C

TRPA1 Polyclonal Antibody Store at -20°C
SKU: E-AB-16104-200
TRPA1 Polyclonal Antibody Store at -20°C
| SKU # | E-AB-16104 |
| Reactivity | Human |
| Host | Rabbit |
| Applications | IHC |
Product Details
| Isotype | IgG |
| Host | Rabbit |
| Reactivity | Human |
| Applications | IHC |
| Clonality | Polyclonal |
| Immunogen | Synthetic peptide of human TRPA1 |
| Abbre | TRPA1 |
| Synonyms | ANKTM 1, ANKTM1, Ankyrin-like with transmembrane domains protein 1, TRPA 1, TRPA1, Transformation sensitive protein p120, Transformation-sensitive protein p120, Transient receptor potential cation channel subfamily A member 1, Trpa1 |
| Swissprot | |
| Cellular Localization | Membrane. |
| Concentration | 0.4 mg/mL |
| Buffer | Phosphate buffered solution, pH 7.4, containing 0.05% stabilizer and 50% glycerol. |
| Purification Method | Affinity purification |
| Research Areas | Cancer, Neuroscience |
| Conjugation | Unconjugated |
| Storage | Store at -20°C Valid for 12 months. Avoid freeze / thaw cycles. |
| Shipping | The product is shipped with ice pack,upon receipt,store it immediately at the temperature recommended. |
Related Reagents
| Applications | Recommended Dilution |
| IHC | 1:25-1:100 |
Background
The structure of the protein encoded by this gene is highly related to both the protein ankyrin and transmembrane proteins. The specific function of this protein has not yet been determined; however, studies indicate the function may involve a role in signal transduction and growth control.